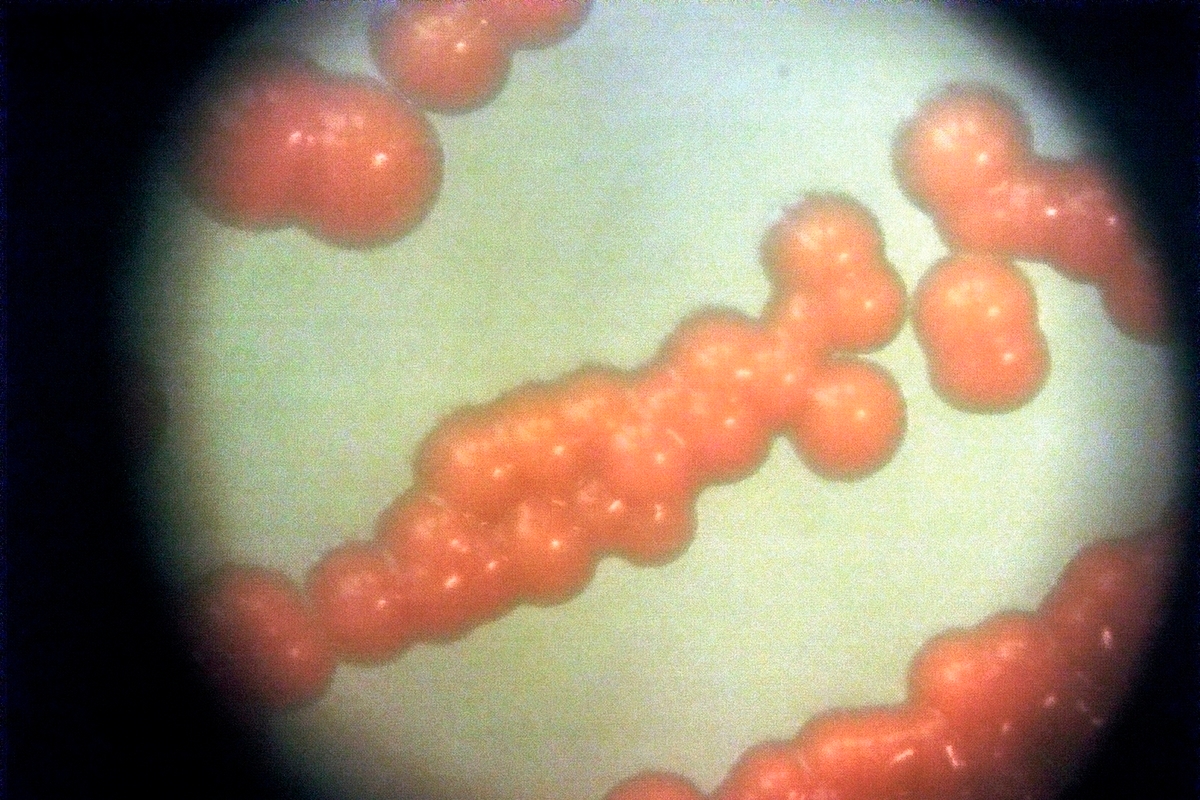

Bilim insanları Napolyon'un ordusunu neyin yok ettiğini buldu.
ABC: Bakteriler Napolyon'un ordusunun yıkımına katkıda bulundu

başlık görselinin altındaki test pankartı
ABC'nin haberine göre bilim insanları, Napolyon Bonapart'ın ordusunun 1812'de yok olmasına birkaç bakteri türünün katkıda bulunduğunu keşfetti.
Gazeteciler, bilim insanlarının 24 yıl önce Vilnius'ta bulunan toplu mezardan alınan asker kalıntılarından örnekler üzerinde çalıştığını belirtti.
Sonunda, 12 cesedin her birinin Salmonella paratyphi tip C ve Borrelia relapsingii ile enfekte olduğu keşfedildi. Bu bakteriler, bit gibi kan emen parazitler tarafından bulaşır.
mk.ru